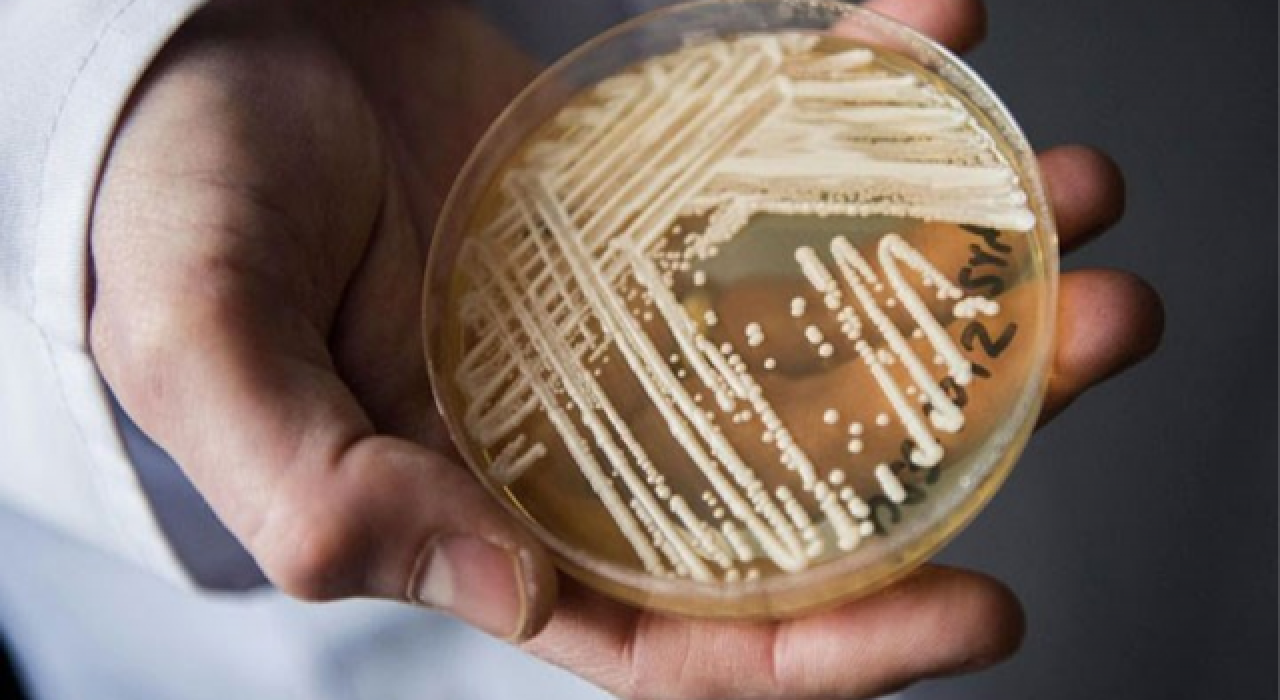
ABD'de ilaçlara karşı dirençli süper mantar hızla yayılıyor

Independent Türkçe'nin aktardığına göre, Washington'daki bir bakımevinde ve Teksas eyaletine bağlı Dallas şehrindeki iki hastanede, ilk kez 2009'da Asya'da tanımlanan yeni bir mantar enfeksiyonu olan Candida auris salgınları bildirildi.
Vakalardan bazıları üç ana ilaç sınıfının hepsine karşı dayanıklıydı.
ABD Hastalık Kontrol ve Önleme Merkezi'nin (Centers for Disease Control and Prevention - CDC) tıbbi yetkililerinden Dr. Meghan Lyman, "Direniş kümelenmelerini gerçekten ilk kez görmeye başladık" dedi. Bu, hastaların enfeksiyonu birbirlerinden kapabileceği anlamına geliyor.
Candida auris, ciddi tıbbi sorunları bulunan hastane ve bakımevi hastaları için tehlikeli addedilen zararlı bir mantar türü. Kan dolaşımına, kalbe veya beyne nüfuz ettiğinde çoğunlukla ölümcül oluyor. Ateş ve titreme gibi belirtiler antibiyotik tedavisinden sonra da devam ediyor.
CDC'nin "acil" tehdit diye sınıflandırdığı mantarın sağlık tesislerinde başlattığı salgınlar, hastayla temasla ya da kontamine olmuş yüzeylerle yayılıyor.
Sağlık yetkileri, yaygın kullanılan ilaçların enfeksiyonlar üzerinde az etkisinin bulunduğunu görmelerinden bu yana söz konusu süper mantarla ilgili uyarılarda bulunuyor.
New York'ta 2019'da hekimler, son savunma hattı olarak kabul edilen ve ekinokandin ismi verilen ilaç sınıfına da dirençli üç vakayı teşhis etmişti.
Bu vakalarda enfeksiyonların hastadan hastaya yayıldığına dair herhangi bir kanıt bulunmamıştı. Bilim insanları ilaçlara karşı direncin tedavi sırasında geliştiği sonucuna varmıştı.
Ancak CDC, bu yılın ocak ve nisan ayları arasında görülen bu yeni tedavi edilemez vakalar hastalar arasında yayıldığını bildirdi.
Washington'da ağır hasta hastalara yönelik bir bakımevindeki 101 Candida auris vakasından oluşan bir küme, üç tür mantar önleyici ilacın hepsine dirençli üç hasta içeriyordu. Dallas bölgesinde iki hastanedeki 22 vakalık bir kümede, aynı direnç seviyesine sahip iki hasta tespit edildi. Bu tesislerin isimleri paylaşılmadı.
Tedaviye tamamen dirençli 5 kişiden üçü (İkisi Teksas'ta ve biri Washington'da) öldü.
Dr. Lyman, ikisinin de devam eden salgınlar olduğunu ve nisandan bu yana yeni enfeksiyonların da tespit edildiğini söyledi. Bu eklenen sayılar açıklanmadı.
Araştırmacılar tıbbi kayıtları gözden geçirdi ve bu kümelerdeki hastalarda enfeksiyon öncesi mantar önleyici ilaç kullanımına dair hiçbir kanıt bulamadı. Sağlık yetkilileri bunun enfeksiyonların kişiden kişiye yayıldığı anlamına geldiğini belirtiyor.